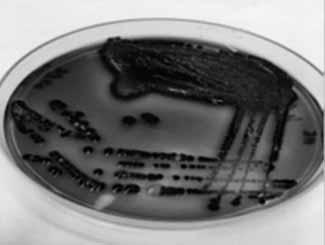
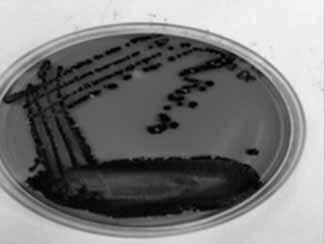
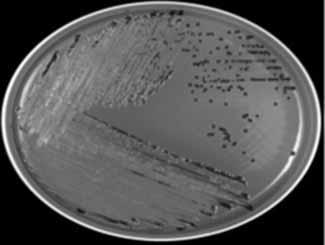

17 minute read
Mare Remm, Mai Treial, Eerik Jõgi, Marika Külm, Triin Aasmäe, Anneli Raave-Sepp, Evi Aotäht
ARTIKLID RAKENDUSUURINGUTEST BIOANALÜÜTIKUTE ÕPPELABORI METOODILISTE JUHENDITE JA ÕPPELABORI KÄSIRAAMATU KOOSTAMINE
Compiling methodological instructions and a handbook for the study laboratory of biomedical scientists in Tartu Health Care College
Advertisement
Mare Remm, Mai Treial, Eerik Jõgi, Marika Külm, Triin Aasmäe, Anneli Raave-Sepp, Evi Aotäht
Abstract
The aims of the study are: compiling methodological instructions which will be used in the study laboratory of Tartu Health Care College, testing their quality and compiling a handbook of the study laboratory based on the instructions, which would be both learning material for the students and teaching material for the lecturers. As the researches are conducted during the studies, they should guarantee mastering the right working methods. Therefore, the instructions used in our laboratories must be both learning materials and handbooks for work, helping students to conduct correct and quality research and receive truthful results.
The methods vary by discipline and laboratory. Compilation of the content of instructions was based on: the ISO standard 15189:2012, the ADDIE (Analyse, Design, Development, Implementation, Evaluation) design model of learning materials, learning outcomes of the curricula of bioanalytical scientists, scientific publications, handbooks of different Estonian hospital laboratories. The work process started with compiling and testing the instructions by the authors. Adaptation methodology was based on the following criteria: length of the analyses, safety, consumption and cost of materials, availability of
technical base, diversity of learned experience. It was followed by expert testing mostly by some practising biomedical scientists and biomedical students. The process ended with evaluation of the methods using the LORI (Learning Object Review Instrument) evaluation model and applying the required corrections.
As the result of the applied study 17 students have compiled 15 sets of instructions so far, each giving a precise description of the work process. The instructions form the main part of the laboratory handbook of quality. There are 5 sets of instructions in histopathology and cytopathology, 5 including 3 study videos in haematology, 2 in molecular diagnostics, 3 in microbiology. The student authors have learnt how to compile methodical instructions, how to control if the instructions work in real life and how to evaluate them and use feedback. The instructions offer future students great materials for independent learning. The study helps us to improve student learning in our study laboratories to the quality of an accredited laboratory where our students will work as professionals in the future.
Keywords: methodical instruction, laboratory quality, evaluation of methodical instruction.
Sissejuhatus
Tartu Tervishoiu Kõrgkoolis on labor, mis omakorda sisaldab mikrobioloogia, kliinilise keemia, hematoloogia, molekulaardiagnostika ja patoloogia allüksuseid. Kõikides laborites viiakse läbi õppeotstarbelisi laboratoorseid uuringuid, mille metoodika peab olema samalaadne tervishoiulaborites tehtavate uuringutega. Kuna tegemist on õppetöö raames korraldatavate uuringutega, peavad need tagama töövõtete omandamise. Seega peavad meie laborites kasutatavad juhendmaterjalid olema nii õppematerjalid kui ka tööjuhendid, mis aitavad üliõpilasel kiiresti, korrektselt ja kvaliteetselt viia läbi uuringuid ning saada tõeseid tulemusi. Praeguse rakendusuuringu puhul ei ole esikohal uus teaduslik tulem, vaid pigem rakenduslik pool ehk õppetöö kvaliteedi tagamine ning heade teoreetiliste teadmiste ja praktiliste oskustega lõpetajad, kes suunduvad
ARTIKLID RAKENDUSUURINGUTEST
tööle tervishoiulaboritesse. Seetõttu ei leia me analoogseid uuringuid teadusuuringute hulgast, vaid vaatame pigem rakenduste suunas. Eeskujuna saame kasutada metoodiliste materjalide koostamise juhiseid, samuti laborite käsiraamatuid. Tõsi, meie eesmärk ei ühti päris nende käsiraamatute omaga, kuid see ei takista kasutamast neid eeskujuna. Igat konkreetset metoodilist juhendit koostades peavad üliõpilased kasutama vastava valdkonna teadusuuringuid.
Rakendusuuringu eesmärk on Tartu Tervishoiu Kõrgkooli õppelaboris kasutatavate metoodiliste juhendite koostamine, kvaliteedi kontrollimine ja nende põhjal õppelabori käsiraamatu kokkupanek, mis oleks õppevahendiks üliõpilastele ja abivahendiks õppejõududele. Esmane ülesanne on üliõpilaste ja õppejõudude ühiste jõupingutustega õppetöös kasutatavate metoodiliste juhendite koostamine ning nende kvaliteedi kontrollimine. Üliõpilaste kohustuseks jääb lõplikult valmis ja ühtselt vormistatud metoodiliste juhendite esitamine. Seejärel rakendame need juhendid kohe töösse. Viimane ülesanne on juhendite alusel valmiva õppelabori käsiraamatu kokkukirjutamine, mille käigus toimub metoodiliste juhendite ülevaatamine ning raamatuks vormistamine. Esialgu ei ole me veel nii kaugele jõudnud, kuid suur hulk juhendeid on valminud ja juba kasutusel. Senini on valminud 15 juhendit, mille koostamisel on osalenud 17 üliõpilast ning seitse õppejõudu, veel on valmimas kaks juhendit ja teemade valimine jätkub.
Õppelabori käsiraamat on vajalik kvaliteetse laboritöö tagamiseks. See võimaldab üliõpilastel iseseisvalt süveneda töövõtete harjutamisse ja õppejõududel (eriti uutel) saada ülevaate laboris toimuvatest praktilistest töödest, nende käigust ning kvaliteedist. Seetõttu on lähtutud laboristandardist „Meditsiinilaborid. Kvaliteedi ja kompetentsuse nõuded“ EVS-EN ISO 15189:2012 järgi (edaspidi ISO standard 15189:2012). Kuivõrd Eestis on üksainus bioanalüütikuid koolitav õppeasutus, nimelt Tartu Tervishoiu Kõrgkool, siis ei ole meil õppelaborite juhendite koostamisel võimalik kasutada haiglalaborite tööjuhendeid, sest need ei ole õppelaborid. Seega
peavad meie juhendid sisaldama ka metoodikate õpetamist, mida haiglalaborite juhendites ei ole, vähemalt mitte nii pikalt ja põhjalikult kui meie juhendites. Samas peavad juhendid arvestama konkreetse labori tingimusi, mis on igas laboris erilised, nii ka meie laborites. Teisalt ei ole meil ainukoolitajana ka partnerit, kellele juhendite kirjutamisel toetuda ja koostööd teha.
Materjal ja metoodika
Nüüdseks on koostatavate juhendite struktuurse ja metoodilise ühtsuse tagamiseks lisatud bioanalüütikute lõputööde juhendisse täiendava osana ka metoodiliste juhendite koostamise õpetus. Olemasolevad kogemused on näidanud, missugustest osadest peab koosnema metoodilise juhendi koostamise protsess ja kuidas juhendi kvaliteeti kontrollida. Töö algab tõenduspõhise kirjanduse läbitöötamisega ja jätkub juhendi kokkupanekuga. Pärast seda hindavad juhendit erinevad eksperdid. Saadud hinnangute alusel tehakse parandused. Töö lõpeb metoodilise juhendi vormistamisega ühtsete vormistusnõuete kohaselt. Kuna ekspertidena kaasatakse nii üliõpilasi kui ka kogenud laborante/bioanalüütikuid, siis toimub juhendi hindamine iga hindaja pädevuse ja teadmiste kohaselt. Kuivõrd juhendid koostatakse lõputööde raames, siis vormistatakse lõputööna ka kogu töö käik.
Juhendite sisulisel koostamisel lähtuti ISO standardist 15189:2012, õppematerjalide koostamise mudelist ADDIE (Analyse, Design, Development, Implementation, Evaluation) (Bater 2015), Tartu Tervishoiu Kõrgkooli bioanalüütiku õppekava õppeainete õpiväljunditest, teadusartiklitest ja erinevate Eesti haiglalaborite käsiraamatutest. Ükski metoodika tervikuna ei sobinud koolilaboris kasutamiseks, sest kirjandusest leitud ja haiglalaborite juhendid on mõeldud töökogemusega spetsialistidele ega ole üliõpilaste jaoks piisavalt üksikasjalised. Esmalt katsetati koolilaboris erinevaid kasutusel olevaid analüüsimeetodeid. Tulemuste alusel valiti välja metoodika, mis kohandati õppelabori tingimustega. Metoodika kohandamisel arvestati järgmiste kriteeriumitega: analüüsi ajaline kestus,
ARTIKLID RAKENDUSUURINGUTEST
ohutus, materjali kulu ja maksumus, tehnilise baasi olemasolu, saadava kogemuse mitmekesisus ning võimaluse korral ka sarnasus haiglates kasutatavate metoodikatega. Valminud juhendites kirjeldati analüüsi eesmärki, selgitati analüüsiga seotud ohte, materjali kogumise ja säilitamise nõudeid, tööetappe ning selleks vajalikke vahendeid. Mõnesse juhendisse lisati abimaterjalid, mis aitavad üliõpilasel varem omandatud materjali meelde tuletada. Teise on lisatud fotod, millel on näha, missugune peab olema tulemus, või on kirjeldatud, missuguse tulemuseni peab üliõpilane uuringu antud etapis jõudma ja kuidas uuringut jätkata. Valminud juhendit/õppefilmi hindasid eksperdid. Ekspertide valimisel lähtuti sellest, et koostatud juhendit/õppefilmi hindaksid töötavad kogenud bioanalüütikud ja erineva õppimistaustaga bioanalüütiku õppekava üliõpilased.
Molekulaardiagnostika alaste juhendite õppeotstarbeline koostamine on mõneti erinev meditsiinilaborites kasutatavatest juhenditest. Viimaste puhul on aina ulatuslikumaks saanud suundumus kommertsiaalsete komplektide kasutamisele, mille puhul on selge küll meetodi põhimõte, aga mitte alati täpne sisu (lahuste täpne keemiline koostis, kasutatud praimerid jne). Õppeotstarbelised juhendid vajavad seevastu täpselt defineeritud sisu ja iga etapi kirjeldust, et üliõpilane saaks aru, kuidas täpselt lõpptulemuseni jõutakse. Juhendi koostamisel oli üliõpilasel vaja leida kirjandusest sobiv metoodika, mida kohandada kasutamiseks kõrgkooli laboris. Erinevates laborites (sealhulgas kõrgkooli laboris) on erinev seadmestik, erinevate tootjate kemikaalid ja ensüümid, mis kõik vajavad toimiva juhendi komplekteerimiseks katsetamist ning optimeerimist.
Õppefilmide valmistamisel kasutati varem bioanalüütiku õppekava järgi koostatud metoodilisi juhendeid. Animatsioonide stsenaariumi koostamiseks otsiti teoreetilisi taustandmeid kirjandusallikatest, mille leidmiseks kasutati erinevaid andmebaase. Stsenaariumite vormistamise juhised saadi juhendaja A. Rosenbergilt, kes soovitas need koostada tabeli vormis: 1) töö, 2) kaadri number, 3) kaadri plaan, 4) tegevus, 5) tekst. Animatsioonide tegemiseks kasutati arvutiprogramme Adobe After Effects CC,
Adobe Illustrator CC ja Adobe Photoshop CC ning lisaks veebikeskkonda (http://www.freepik.com), kus on lubatud tasuta allalaadimine. Õppefilmide helindamiseks kasutati arvutiprogrammi Audacity. Õppefilmid filmiti Tartu Tervishoiu Kõrgkooli õppelaboris ja osa animatsioonide seadmetest, tarvikutest ning reagentidest tagas SYNLAB OÜ.
Erinevate õppematerjalide kvaliteeti hindavate mudelite seast otsustati juhendite hindamiseks kasutada LORI (ingl The Learning Object Review Instrument) mudelit (Põldoja 2016). LORI mudelile (Nesbit jt I.a.) ja teemakohasele kirjandusele tuginedes koostati hindamisleht, mis võimaldas ekspertidel anda hinnangu Likerti 5-pallisel skaalal. Koostatud küsimuste abil sai hinnata juhendi sobivust õpiväljunditega, struktuurset ülesehitust, informatiivsust, loogilisust, korrektsust, teabe leidmise lihtsust, õppimise tulemuslikkuse parendamist ja kasutatavust kooskõlas juhendi eesmärkidega. Peale selle hinnati juhendis olevate jooniste, fotode, skeemide ja tabelite sobivust. Ekspertidelt saadud vastuste analüüsi ja tehtud ettepanekute põhjal viidi juhenditesse sisse vajalikud parandused ning muudatused.
Õppefilmide hindamiseks koostati küsitlus ja sisestati veebikeskkonda www.connect.ee. Õppefilmi hindamiseks said bioanalüütiku õppekava tudengid veebikeskkonnas oleva küsitluse ja õppefilmi veebilingi sotsiaalmeedia vahendusel.
Tulemused
Praeguseks on valminud 15 juhendit, mille koostamisel osales 17 üliõpilast. Meie eesmärk ei olnud saada sama palju juhendeid eri valdkondades. Mikrobioloogia ja molekulaardiagnostika valdkonnas on juhendite koostamine hoo sisse saanud alles viimastel aastatel, samas hematoloogia ja patoloogia valdkonnas asusid üliõpilased rakendusuuringu raames kohe juhendeid koostama (tabel 1). Mitut juhendit on ühe valdkonna tarbeks vaja? Ega ei oskagi öelda, kuid arvame, et viie-kuue juhendiga saame vähemalt esialgu hakkama.
Tabel 1. Juhendite valmimise aasta, valdkond ja üliõpilane, kes juhendi koostas
Lõpetamise aasta 2015 Molekulaardiagnostika Patoloogia Mikro- bioloogia Hemato- loogia
O. Pilitsina A. Karus
E. Lepla ja E. Priks
2016 H. Leping E. Selge A. Tammela ja T. Tähe 2017 K. Karlson E. Luik H. Sepp A.-H.-E. Asso R. Lehtmets
2018
E. Oja C. Platonova O. Mamošina M. Stepanenkova
Tulemused hematoloogia valdkonnas
Hematoloogia valdkonnas koostatud juhendid: „Juhend erütrotsüütide settekiiruse määramiseks kapillaarverest …“ (2016), autor E. Selge; „Metoodiliste juhendite koostamine — AB0 ja RH(D)“ (2015), autor A. Karus. Hinnangud nendele juhenditele olid positiivsed, tuues esile fotode ja illustreerivate jooniste vajalikkuse, mis kergendasid tekstist arusaamist. Hindajad leidsid, et joonised peaksid olema värvilised. Seda soovitust võeti arvesse ja kasutatavas juhendis on fotod värvilised.
Üliõpilastest eksperdid hindasid õppefilmide ülesehitust, teksti sõnastust ja arusaadavust heaks või väga heaks. A. Asso filmi „AB0/RH(D) veregruppide määramine BIO-RAD geeltehnikaga“ (2017) hindajad soovitasid lisada subtiitrid ja arvasid, et taustaks kasutatud muusika on liiga uinutav või isegi segav. Hinnangu andmisel kirjutati järgmist: „Jätta kõrvale taustamuusika, keskenduda reaalselt tööle endale“, „Oleks võinud panna natuke teistsugust muusikat, muidu ajab veidi uimaseks“. Heideti ette, et „ei ole lahti seletatud töös esinevaid potentsiaalseid eriolukordi, juhtumeid, kus mingil põhjusel verest tõepoolest korralikku tulemust ei saa. Veregruppide määramisega seoses ka nii-öelda häguseid/segaseid vastuseid.“
E. Lepla ja E. Priksi filmi „Uriinianalüüsi õppefilmid“ (2015) hindajad andsid filmile positiivse hinnangu ning leidsid, et õppefilm võimaldab õppida omas tempos ja seda saab õppetöös kasutada. Õppefilmi tugevaks küljeks peeti järgmist külge: „Saab mitmeid kordi vaadata ja tagasi kerida, kui millestki aru ei saanud.“ Nõrga küljena toodi välja: „Õppefilmi järgi õppimisel ei saa tekkinud küsimustele kohe vastuseid.“
Valdav osa hindajatest leidis, et A. Tammela ja T. Tähe filmis „Õppefilm ja pildikogu uriini sademe mikroskoopimise õppimiseks“ (2016) näidatud tegevused sobivad töövõtete individuaalseks omandamiseks, kuid mikroskoobiga preparaadi pildi kättesaamiseks ei piisa ainult õppefilmist saadud teadmistest, vaid see vajab praktilist kogemust (joonis 1). Seda väidet põhjendati järgmiselt: „Sademe leidu hinnata ainult õppefilmi põhjal ei ole tõenäoliselt reaalne, eriti kui tegu on esmakordse mikroskoopijaga. Vajab siiski ka pildikogumiku abi ja kogemusi.“ „Usun, et pildi kättesaamine nõuab pigem lihtsalt harjutamist, õppefilm ei saagi seda nii täpselt õpetada.“ „Film aitab suuresti aru saada tööprotsessist, kuid praktilist tegevust peab keegi juhendama.“

Joonis 1. Kaltsiumfosfaadi kristallid ja kaltsiumoksalaadi kristallid A. Tammela ja T. Tähe pildikogust
ARTIKLID RAKENDUSUURINGUTEST Tulemused patoloogia (histoloogias ja tsütoloogias) valdkonnas
Patoloogia valdkonnas on koostatud neli värvimisjuhendit: „Van Giesoni värvingumeetodi juhend …“ (2016), autor H. Leping; „Elastsete kiudude värvingu juhend …“ (2017), autor E. Luik; „Neerukoe histoloogilise värvingu juhend …“ (2018), autor E. Oja; ning „Maksa histoloogilise värvingu metoodiline juhend …“ (2018), autor O. Mamošina. Kõik nimetatud juhendid haaravad histoloogiliste preparaatide värvinguid. Esimene kord ebaõnnestus üliõpilastest ekspertidel E. Oja väljavalitud Masson trikroomi värvingumeetodi katsetamine, kuid edaspidi täpsustati loputamisetappi pärast töötlust happelise fuksiinilahusega. Seejärel üliõpilaste katsetused õnnestusid (joonis 2).

Joonis 2. Nooremad üliõpilased kasutasid neerukoe värvimiseks koostatud Masson trikroomi värvingu juhendit (E. Oja) ning said kena sinistes ja punastes toonides neerukoe pildi
Ekspertide täpsustustest ja muutmisettepanekutest oli kahtlemata kasu, sest neid arvestades said lõplikud juhendid esialgsetest paremad ning see kehtis kõigi juhendite puhul. Ekspertide arvates ei peaks värvingumeetodeid kasutama inimesed, kes ei ole ainekava läbinud (gümnaasiumiõpilased). Siinkohal tuleb pöörata tähelepanu juhendaja tegevusele töös gümnaasiumiõpilastega.
Tsütoloogia valdkonnast on seni ainsana oma uuringu teinud O. Pilitsina (joonis 3). Tema tööd „Emakakaela patoloogiliste muutuste diagnostika õppematerjal“ (2015) hindasime sedavõrd vajalikuks, et praeguseks on koostatud sellele tuginedes, seda parandades ja üht-teist lisades elektrooniline käsiraamat „Emakakaela patoloogiliste muutuste diagnostika“ (Pilitsina jt 2016), mis on kättesaadav kõrgkooli kodulehelt. Ekspertide arvamustest lõputöö kohta ilmnes, et nende seisukohalt võiks olla veelgi enam fotosid, näiteks perinukleaarsest halost ja silinderepiteeli erinevatest rakkudest, aga mainitud ka Bethesda süsteemi. Ettepanekuid arvestati nii palju kui võimalik, sest lõputööl on oma mahupiirangud, mida töö vormistamisel tuleb silmas pidada. Samas oli meil hiljem elektroonilist käsiraamatut koostades võimalik pakutud materjale lisada.


Joonis 3. O. Pilitsina fotod lõputööst. Vasakpoolsel fotol on peale lameepiteeli rakkude näha mitmeid Trichomonas vaginalis’e heledaid rakke ja parempoolsel lisaks suurele lameepiteeli rakule ka Candida spp. mütseeli niiti
Tulemused mikrobioloogia valdkonnas. Mikrobioloogia alal on seni valminud kolm õppetöös kasutatavat juhendit: „Uriini mikrobioloogilise analüüsi juhend …“ (2017), autor H. Sepp; „Juhend Salmonella spp. isoleerimiseks ja samastamiseks kliinilisest materjalist“ (2018), autor M. Stepanenkova, (joonis 4); „Staphylococcus spp. samastamise juhend …“ (2018), autor C. Platonova.
ARTIKLID RAKENDUSUURINGUTEST a. b.

c. d.
Joonis 4. Fotod Marina Stepanenkova juhendist Salmonella spp. isoleerimisest ja samastamisest; a) rohelisel Hektoen söötmel olevad mustjad Salmonella spp. kolooniad, b) punasel XLD söötmel on sama bakteri mustjad kolooniad, c) roosal MacConkey söötmel on valkjas-hallikad kolooniad, d) on näha API 20E testi näidis, kus viaalides olev lahus on muutnud oma värvi
Juhendi kui õppevahendi hindamisel on ekspertidena andnud põhjalikuma hinnangu vähem kogenud üliõpilased, ilmselt hindavad nad juhendeid tähelepanelikumalt ja annavad seega põhjalikumat tagasisidet. Eksperdihinnangutest on selgunud, et enamik üliõpilastest hindajaid peab juhendit praktilise töö sooritamisel ja antud teema õppimisel kasulikuks. Juhend annab terviklikuma ülevaate mikroobide samastamise loogikast ja toetab süvateadmiste ning oskuste tõhusamat ja kiiremat
omandamist. Juhendite kasutamist õppetöös on vähemtähtsaks pidanud töötavad bioanalüütikud, arvatavasti juba olemasoleva töökogemuse tõttu. Juhendite hindamisel pidasid üliõpilased väga tähtsaks illustreerivate materjalide või selgitava teksti olemasolu uuringu igas etapis. See andis üliõpilastele teatava kindlustunde, et nad on tööprotsessi õigesti sooritanud. Ekspertide arvates oli teabehulk juhendites optimaalne, tähtsam oli esile tõstetud ja kergesti leitav.
Juhendite puuduste osas olid kõigil kolmel juhul välja toodud kirja- ja vormistusvead. Mõne uuringuetapi tehniliste võtete sooritamisel tundsid üliõpilased end ebakindlalt ja soovisid lisajuhiseid, mida juhend ei pakkunud. Kahe koostatud juhendi puhul on eksperdid toonud välja, et sissejuhatuses võiks olla teavet samastatavate bakteriliikide kohta.
Tulemused molekulaardiagnostika valdkonnas
Kahel tudengil valmis töö molekulaardiagnostika alaste juhendite koostamise kohta: „Faktor V Leideni mutatsiooni PCR-RFLP diagnostika metoodiline juhendi koostamine … “ (2017), koostaja K. Karlson; „Inimese verest DNA eraldamise metoodiline juhend …“ (2017), autor R. Lehtmets. Mõlemad valminud juhendid olid väga põhjalikud ja sobivad õppetöös kasutamiseks (joonis 5). Lisaks andis juhendite koostamine üliõpilastele väärtusliku kogemuse uute metoodikate rakendamisel ja vormistamisel laborikeskkonnas.
ARTIKLID RAKENDUSUURINGUTEST
Faktor V Leideni mutatsiooni PCR-RFLP diagnostika /…/ K. Karlson
Inimese verest DNA eraldamise metoodiline /…/ R. Lehtmets


Joonis 5. Plokkskeemid, mis iseloomustavad molekulaardiagnostika alaste juhendite tööde etappe
Arutelu
Senini on meil koostatud ja hinnatud 15 metoodilist juhendit, sealhulgas ka günekotsütoloogiline käsiraamat ja filmid. Nende lühiiseloomustus on antud eespool. Kõik nimetatud juhendid on töösse rakendatud. Ühtlasi on 2018. aastal Baltimaade laborimeditsiini kongressil Vilniuses peetud üks ettekanne rakendusuuringu kohta ja kongressi kogumikus ilmus trükitud kokkuvõte (Remm jt 2018). Meie rakendusuuringu sihiks on jõuda õppelabori käsiraamatuni. Sinnamaale me veel jõudnud ei ole, kuid töö edeneb ja loodame jõuda ka käsiraamatu koostamiseni.
Juhendil õppevahendina on üliõpilaste arvates teoreetiliste teadmiste omandamisel ja praktiliste ülesannete sooritamisel tähtis osa. Juhendis ilmnenud vigade parandamisel oli üliõpilaste eksperdihinnangust võrreldes töötavate bioanalüütikutega pigem abi, sest nad andsid põhjalikuma
ja kriitilisema tagasiside oma väiksema kogemuse tõttu mikroobide samastamisel. Arvatavasti on põhjuseks asjaolu, et töötavad bioanalüütikud on kogenumad ja tuginevad vähem juhenditele. Teisalt oskavad nad näha ka laiemat pilti ning kui juhendist puudusid näiteks ohumärgised, siis panid nad seda tähele ja toonitasid nende vajalikkust. Üliõpilased hindasid seda, et juhendi järgi töötades sai tervikliku pildi tööprotsessist ja mikroobide samastamise loogikast. Selle saavutamisele aitasid kaasa juhendi struktuurne ülesehitus ja optimaalne sisu. Seega on põhjendatud mõlema eksperdirühma kasutamine, sest nende vaate ulatus ja märkamisvõime on erinevad.
Eksperdihinnangust lähtuvalt soovis osa eksperte viia juhendi sissejuhatavasse ossa rohkem teavet samastatavate mikroobide kohta. Seda täiendust ei tehtud, sest metoodilised juhendid on koostatud uuringuprotsessi kirjeldamiseks. Teoreetilised teadmised juhendis käsitletud teemade kohta on eelnevalt läbitud. Samas on üliõpilaste piisava teadmistepagasi tagamiseks tekkinud idee luua elektroonne õppevahend, mille linkide kaudu on võimalik leida uuringut puudutavat teoreetilist teavet.
Õppefilmi kvaliteet olenes koolis kasutatavast tehnikast ja autorite teadmistest ning oskustest. Kuna teave filmimistehnika kohta tugines põhiliselt internetis olevatele materjalidele, siis ei ole õppevahendi tehniline teostus piisavalt professionaalne, kuid annab vajaliku info edasi. Filmide autoritel puudusid põhjalikud monteerimisoskused, mis põhjustas sujuvuse osas kvaliteedi halvenemise. Vaatamata tehnilistele puudustele on kõik valminud filmid õppetöös kasutusel.
Reimo Lehtmetsa lõputöö „Inimese verest DNA eraldamise metoodiline juhend …“ (2018) sisaldab üksikasjalikku juhendit vereproovist DNA eraldamise kohta. Selle juhendi abil on tudengil võimalik ette valmistada vajalikud lahused ja läbi viia DNA eraldamise protsess. DNA eraldamise juhendi metoodika ettevalmistamine oli ootamatult töömahukas protsess, mis hõlmas vajadust saada metoodika laboris rutiinselt tööle.
ARTIKLID RAKENDUSUURINGUTEST
Kohandamist vajasid kasutatavate lahuste hulgad (antud juhul skaleeriti eraldamise maht väiksemaks, et sobituda väiksemate katsutitega). Lisaks tehti võrdluskatsed alternatiivsete meetoditega (kommertsiaalne DNA eraldamise komplekt, orgaaniline DNA ekstraktsioon).
Kätlin Karlsoni lõputöö „ Faktor V Leideni mutatsiooni PCR-RFLP diagnostika metoodiline juhend …“ (2017) sisaldab endas nii PCR-metoodikat DNA lõigu amplifikatsiooniks kui ka saadud DNA lõigu hilisemat analüüsi restriktaasi abil (restriction fragment lengt polymorphism). Juhendi koostamise käigus selgus, et kirjanduses toodud meetodid vajavad modifitseerimist ja kohandamist – muutusi oli vaja sisse viia nii PCR-metoodikasse kui ka restriktsioonanalüüsi, et juhendi järgi saaks töötada ka meie laboris kasutatavate kemikaalide ja seadmetega. Mõneti keerulisemaks osutus analüüsi lõpetamiseks vajalik DNA elektroforees, sest meie laboris kasutatavad seadmed ei võimaldanud piisavat lahutusvõimet ja vajalikuks osutus agaroosgeeli asemel akrüülamiidgeeli kasutamine. Põhimõtteliselt sarnaseid ootamatusi, et üks või teine metoodika või selle osa ei sobi meie labori jaoks, kogesid ilmselt kõik juhendite koostajad.
Juhendite hindamisel osalenud bioanalüütiku eriala tudengid olid valminud juhenditega üldiselt rahul ja hindasid juhendeid nii molekulaardiagnostika ja geneetika õppelaboris kui ka teistes laborites kasutamiseks sobivateks.
Kokkuvõte
Rakendusuuringu käigus koostati juhendid, mis toetavad üliõpilaste õppimisprotsessi. Juhendite koostajad said kogemuse metoodilise juhendi väljatöötamiseks. Laboris töötavad inimesed, kes on juba õppimise käigus juhendeid koostanud ja ilmselt valmis seda ka edaspidi tegema.
Allikaloend
Asso, A-H-E. (2017). Õppefilmi „AB0/RH (d) veregruppide määramine Bio-Rad geeltehnikal“ sobivuse hindamine. Tartu Tervishoiu Kõrgkool, bioanalüütiku õppekava.
Tartu. Lõputöö. Bater, A.W. (T.). (2015). Teaching in a Digital Age. Guidelines for designing teaching and learning. BCcampus. https://open.umn.edu/opentextbooks/textbooks/teachingin-a-digital-age-guidelines-for-designing-teaching-and-learning-for-a-digital-age Karlson, K. (2017). Faktor V Leideni mutatsiooni PCR-RFLP diagnostika metoodilise juhendi koostamine Tartu Tervishoiu Kõrgkooli geneetika ja molekulaardiagnostika õppelaboris kasutamiseks. Tartu Tervishoiu Kõrgkool, bioanalüütiku õppekava.
Tartu. Lõputöö. Karus, A. (2015). Metoodiliste juhendite koostamine — AB0 ja RH(D) määramiseks ning erütrotsütaarsete antikehade sõeluuringuks. Tartu Tervishoiu Kõrgkool, bioanalüütiku õppekava. Tartu. Lõputöö. Lehtmets, R. (2017). Inimese verest DNA eraldamise metoodiline juhend Tartu Tervishoiu Kõrgkooli molekulaardiagnostika õppelaboris kasutamiseks. Tartu Tervishoiu
Kõrgkool, bioanalüütiku õppekava. Tartu. Lõputöö. Leping, H. (2016). Van Giesoni värvingumeetodi juhend Tartu Tervishoiu Kõrgkooli patoloogia laboris kasutamiseks. Tartu Tervishoiu Kõrgkool, bioanalüütiku õppekava. Tartu. Lõputöö. Lepla, E., Priks, E. (2015). Uriinianalüüsi õppefilmid. Tartu Tervishoiu Kõrgkool, bioanalüütiku õppekava. Tartu. Lõputöö. Luik, E. 2017. Elastsete kiudude värvingu juhend Tartu Tervishoiu Kõrgkooli praktikumides kasutamiseks. Tartu Tervishoiu Kõrgkool, bioanalüütiku õppekava. Tartu.
Lõputöö. Mamošina, O. (2018). Maksa histoloogilise värvingu metoodilise juhendi koostamine
Tartu Tervishoiu Kõrgkooli patoloogia laboris kasutamiseks. Tartu Tervishoiu
Kõrgkool, bioanalüütiku õppekava. Tartu. Lõputöö. Meditsiinilaborid. Kvaliteedi ja kompetentsuse nõuded EVS-EN ISO 15189:2012. (2012). Eesti Standardikeskus. Nesbit, J. Belfer, K. Leacock, T. (I.a). Learning Object Review Instrument (LORI). User
Manual. Version 1.5.
Oja, E. (2018). Neerukoe histoloogilise värvingu koostamine Tartu Tervishoiu Kõrgkooli patoloogia laboris kasutamiseks. Tartu Tervishoiu Kõrgkool, bioanalüütiku õppekava. Tartu. Lõputöö. Pilitsina, O. (2015). Emakakaela patoloogiliste muutuste diagnostika õppematerjal.
Tartu Tervishoiu Kõrgkool, bioanalüütiku õppekava. Tartu. Lõputöö. Pilitsina. O., Tamm, H., Remm, M., (2016). Emakakaela patoloogiliste muutuste diagnostika. Käsiraamat. http://www.nooruse.ee/gynekotsytoloogia.pdf Platonova, C. (2018). Staphylococcus spp. samastamise juhend Tartu Tervishoiu Kõrgkooli mikrobioloogia laboris kasutamiseks. Tartu Tervishoiu Kõrgkool, bioanalüütiku õppekava. Tartu. Lõputöö. Põldoja, H. (2016). Õppematerjalide koostamise protsess ja kvaliteet. https://oppematerjalid.wordpress.com/oppematerjalid/oppematerjalide-koostamise-protsessja-kvaliteet/ Remm, M., Raave-Sepp, A., Treial, M., Jõgi, E., Orav, A., Aotäht, E., Külm, M., Aasmäe,
T. (2018). Compiling a Handbook of Methodical Instructions of Study Laboratory for Biomedical Scientists in Tartu Health Care College. Laboratorinė Medicina 20,
Special Supplement: 37. Selge, E. (2016). Juhend erütrotsüütide settekiiruse määramiseks kapillaarverest Tartu
Tervishoiu Kõrgkooli hematoloogia praktikumides kasutamiseks. Tartu Tervishoiu
Kõrgkool, bioanalüütiku õppekava. Tartu. Lõputöö. Sepp, H. (2017). Uriini mikrobioloogilise analüüsi juhend Tartu Tervishoiu Kõrgkooli mikrobioloogia laboris kasutamiseks. Tartu Tervishoiu Kõrgkool, bioanalüütiku õppekava. Tartu. Lõputöö. Stepanenkova, M. (2018) Juhend Salmonella spp. isoleerimiseks ja samastamiseks kliinilisest materjalist. Tartu Tervishoiu Kõrgkool, bioanalüütiku õppekava. Tartu.
Lõputöö. Tammela, A., Tähe, T. (2016). Õppefilm ja pildikogu uriini sademe mikroskopeerimise õppimiseks. Tartu Tervishoiu Kõrgkool, bioanalüütiku õppekava. Tartu. Lõputöö.